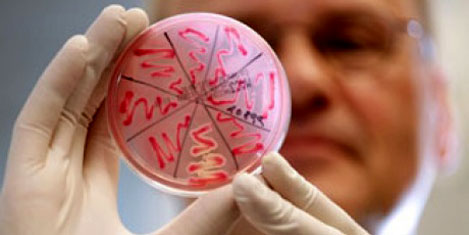
ehec-virusu.jpg

İSTANBUL - Almanya'da ağır bağırsak enfeksiyonuna ve ölümlere de neden olabilen EHEC bakterisinden kaynaklanan hastalıklardan ölenlerin sayısı 8'e yükseldi.
Son olarak Schleswig-Holstein eyaletinde 38 yaşındaki bir genç kadın ile Hamburg kentinde 87 yaşındaki bir kadının EHEC bakterisinin sebep olduğu HUS sendromundan dolayı hayatını kaybettiği bildirildi.
Almanya'da yaklaşık 1000 kişiye EHEC bakterisinin bulaştığı tahmin ediliyor. Bakteriyel hastalıkların sayısının Almanya'da normalde her yıl 900 civarında olduğu belirtildi.
EHEC bakterisi, şu ana kadar sadece İspanya'dan ithal edilen salatalıklarda tespit edildi. Bu nedenle aralarında Metro gibi büyük alışveriş marketlerinin bulunduğu bazı süpermarketler reyonlarından bu salatalıkları kaldırdı.
EHEC paniği Kuzey Avrupa'ya da sıçradı.
İshal ve böbrek yetmezliğine neden olan EHEC bakterisi, Almanya'dan sonra İsveç, Danimarka, İngiltere ve Hollanda'da da görüldü.
İsveç'te on, Danimarka'da dört, İngiltere'de üç, Hollanda'da bir kişide EHEC basili bulunduğu açıklandı. İngiltere Sağlık Koruma Ajansı, virüsün genellikle yetişkinleri etkilediğini, hastaların yüzde 70'inin kadın olduğunu açıkladı.
İngiltere'de 7 kişide EHEC salgını
LONDRA - İngiltere Sağlık Koruma Ajansı (HPA), ülkede Almanya'yı yakın zamanda ziyaret eden ya da Alman vatandaşı olan toplam 7 kişide, E. coli virüsünün tespit edildiğini açıkladı.
Ajans, virüse İngiltere'deki sebzelerde rastlanmadığını belirtirken, Almanya'ya seyahat edecek İngiliz vatandaşlarına çiğ sebze ve salata yememeleri önerildi. Sağlık Ajansı ayrıca, sebze ve meyvelerin yenmeden önce yıkanmasını, sebzelerin pişirilerek ve kabukları soyularak yenilmesini ve ellerin sıkça yıkanmasını tavsiye ediyor.
Mide bulantısı, kusma ve ishalle ortaya çıkan ve bir bakterinden kaynaklandığı bildirilen EHEC salgınının, Almanya ve diğer Avrupa ülkelerine yayıldığına dikkat çekiliyor.
SEBEP DEVRİLEN BİR SANDIK MI
EHEC virüsünün kaynağının, İspanya'dan ithal edilen salatalık olduğu belirlenmişti. Salatalıkların üreticisi Pepino Bio Frunet firması ise bu suçlamaları geri çevirdi. Firma söz konusu salatalıkların nakliyat sırasında devrildiğini ve virüsün bu şekilde bulaşmış olabileceğini belirtti.
Tehlikeli Ehec virüsü Almanya'yı sarmaya başladı
Almanya'da EHEC isimli yeni bir virüs kafaları karıştırmaya devam ediyor, Alman Doktor Dr. Jan Kielstein birçok kişinin EHEC virüsünden hayatını kaybedebileceğini açıkladı.
EHEC Virüsü'nün şuana kadar henüz net olarak nereden geldiği belli değil ancak yetkililer bu virüsün Hayvan dışkısı üzerinden yayılmış olabileceği kanaatinde.
Sebzeler için kullanılan Bio ( Organik ) gübreler içerisinde aynı tehlikenin olabileceğini ve bu durumda virüsün daha çok yayılmasından endişe ediliyor.
Birkaç gün içerisinde Almanya genelinde 300 Hasta aynı virüsten hastanelerde yatıyor, hatta bazı hastalar şuan ölümle pençeleşiyor denildi.
Hamburg Sağlık Kurumu durumun çok ciddi olduğunu ve antibiyotik önlemlerinin EHEC Virüsü karşısında hiç bir etkisinin olmadığını açıkladı. Sağlık uzmanları gübreli sebzelerden korunmak adına cok iyi temizlenmesi ve çok iyi haşlanmış olması gerektiğini söyledi. Virüsün, direk olarak bağırsaklara saldırı yaptığını ardından böbrek fonksiyonlarını durdurduğunu ve ölüme götürdügü söylendi. EHEC Virüs haberi diğer Avrupa Ülkelerinden'de gelmeye başladı Türkiyede henüz bir vaka görülmedi fakat yaz aylarının ve Turizmin artmasıyla Türkiye'ye EHEC virüsü girmesi tehlikesi bulunuyor.
Rusya, AB'den sebze ithalatını yasakladı
ANTALYA -Antalya Yaş Meyve Sebze İhracatçı Birliği (AYMSİB) Mustafa Satıcı, İspanyol salatalığında görülen hastalık nedeniyle Almanya ve çeşitli ülkelerde ölümlerin yaşanması üzerine Rusya'nın AB ülkelerinden bugün itibariyle sebze ithalatını yasakladığı bilgisinin geldiğini bildirdi.
Satıcı, Avrupa ve Rusya'da görülen EHEC salgını nedeniyle tüketicilerin endişeli olduklarını ve tüketimin azaldığını ifade etti. Rusya'nın AB ülkelerinden bugün itibariyle sebze ithalatını yasakladığı bilgisinin geldiğini kaydeden Satıcı, Rusya'nın önümüzdeki günlerde AB ülkelerinden meyve ithalatını da yasaklamasının tartışıldığını söyledi.
Türkiye'nin Rusya'ya sebze ihracatının giderek arttığını ifade eden Satıcı, şöyle konuştu:
"AB ülkelerinde salatalıklarda görülen bakteri nedeniyle Rusya vatandaşını korumak amacıyla bugün itibariyle AB'den sebze alımını yasakladı ancak Türkiye'nin Rusya'ya sebze ihracatı giderek artıyor. Türkiye için bir olumsuzluk yok. Zaten artık Rusya'nın sebze ithalatına da ihtiyacı kalmayacak. Çünkü Rusya'nın kendi üretimi devreye girecek.
Rusya'da meyve ithalatının da yasaklanacağı söylentisi var. Rusya, AB ülkelerinden meyve ithalatını yasaklarsa, bu Türkiye açısından olumlu olur. Meyve ihracatımızı artırır."



































Türkçe karakter kullanılmayan ve büyük harflerle yazılmış yorumlar onaylanmamaktadır.